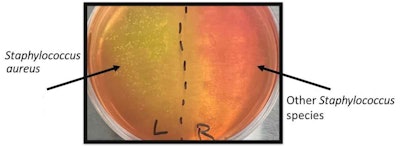
Figure 1. Mannitol salt agar plate incubated with swabs from the nares (nostrils) of an individual with S. aureus growth for the left side and non-S. aureus species growth on the right

The term microbiome was first conceived approximately 22 years ago by Nobel Laureate Joshua Lederberg, Ph.D., who had a storied career as a research microbiologist. Since then, the use of this term has flourished across multiple disciplines and industries. But what is the precise definition of this cross-disciplinary term? It has also spawned an entire vocabulary unto its own with expressions such as microbiota, dysbiosis, biodiversity and biogeography.
Moreover, a significant investment in microbiome research endeavors has been predicated on the commonly described ratio of microbial to human cells; an estimate from 1972 put this average ratio at approximately 10:1.1 But how accurate is that figure? Does it hold up over time given the vast amounts of new data amassed in the last couple of decades?
Massive public endeavors such as the Human Microbiome Project (HMP) and the Earth Microbiome Project (EMP) have certainly contributed to a greater public awareness of the importance and implications of this field of study.2-4 The HMP was launched in two phases starting in 2007 with the stated goal of identifying and characterizing the microbes that reside on and within the human body that have impacts on human health.
The information gleaned from this effort was particularly targeted toward understanding if there was a correlative link between the constituents of the human microbiome and health issues associated with pregnancy, irritable bowel syndrome and the development of diabetes. The EMP has taken charge of an even more daunting task: identifying and cataloguing the planetary microbial community.
All too often, microbiome-related terms become conflated inappropriately and mischaracterized. Worse yet, some groups over-promise the degree of benefits resulting from application of microbiome-targeted products. Without proper correction, this could become a compounding problem for the cosmetic care industry.
Advances in scientific understanding of the human microbiome are published nearly every day, cumulatively adding to the knowledge base and demonstrating that science’s picture of the skin microbiome is far from complete. If consumer confidence is lost in the early stages of these endeavors, how can their faith and interest be restored when the remarkable complexity of the skin microbiome has been finally delineated?
It is the intention of this manuscript to dispel some of the myths surrounding the microbiome, properly define the nomenclature and instill an appreciation for the magnitude of the ongoing research and what has yet to be revealed.
Skin Microbiome vs. Skin Microbiota
Although often used interchangeably, the skin microbiome is technically distinct from the skin microbiota. Collectively, the microbes that take up residence on the skin represent the skin microbiota, which includes traditional bacteria, archaea, fungi and viruses. All of the genetic information contained in the genomes of these resident microbes is technically the skin microbiome. However, many institutions and individuals use the two terms somewhat interchangeably.
The distinction becomes important when returning to the question of the accuracy of the 10:1 ratio of microbial to human cells in the average human body. Revised estimates have changed the ratio to approximately 1.3:1 – nearly an order of magnitude difference. But if one considers the genetic contribution, the ratio returns to the previous 10:1 since roughly 80% of all human cells are red blood cells that, during maturation, dispense with their nuclei and by extension, their genetic complement.5, 6 From this perspective, the microbes that have taken up residence on and inside of our bodies provide a greater diversity of genetic information than our own human cells.
With the constant flurry of new findings in this arena of research, the cosmetic industry has leveraged multiple efforts to develop a series of products that attempt to modulate the microbiome to improve overall skin health. This is a complex proposition at best for a variety of reasons. First and foremost, our knowledge of the resident microbes on the skin remains incomplete, though substantial progress is being made toward the identification and characterization of the microbiota.
Of significance are the various so-called commensal microorganisms that are present on the skin and have either no impact or provide some type of benefit to the host. Many studies have determined that the three most abundant commensal microbes on the skin are two bacterial species: Cutibacterium acnes and Staphylococcus epidermidis; and multiple species of the fungal genera Malassezia.
The early days of delineating skin-resident microbes were limited to only those microorganisms that could be cultured from collected skin samples. The majority of the microbes isolated via this culture-dependent approach were bacteria, which is unsurprising given recent estimates that show traditional (non-archaeal) bacteria vastly outnumber the cell counts of fungi, archaea and the occasional protozoa.
Critically, most biological entities that are found on the skin are not culturable, which narrowed the scope of our identification efforts. It was not until culture-independent sequencing techniques were developed, such as 16S ribosomal RNA (rRNA) and internal transcribed spacer 1 (ITS1), that we could detect a greater variety of bacteria and fungal species, respectively. In more recent years, the advent of metagenomic sequencing, which does not require a specific gene (or amplicon) as a focus, permits the discernment of many more microbes including acellular biological entities such as viruses and satellite viruses that cannot be grown by standard laboratory techniques.
The elucidation of the skin virome also continues to be a new frontier in skin microbiome research. The vast majority of these viruses exclusively target bacterial prokaryotic cells known as bacteriophages – literally “bacteria-consuming,” as have potential application as microbiome modulators.
The viruses that have been identified on skin that can infect eukaryotic human skin cells include various papillomaviruses, polyomaviruses and retroviruses.7 The impact of their presence remains to be fully determined. Of note, these are all DNA-based viruses – i.e., based on the genetic material shared by all cellular life – but there are viruses that use RNA as an alternative genomic material.
Unfortunately, RNA sequencing techniques have not been broadly applied to culture-independent studies of the skin. As such, a comprehensive perspective of the possible complement of RNA-based viruses on the skin remains lacking.
Biodiversity and Biogeography
Frequently the marketing campaigns attached to microbiome modulatory products laud a “restoration of biodiversity,” and that increased biodiversity of the skin microbiome translates to improved skin health. Such statements have been clinically demonstrated to be true in the context of the gut microbiome; particularly so with the 2023 U.S. Food and Drug Administration’s approval of fecal transplants as a probiotic solution to enhance the richness of the microbial population in the gut. However, regarding the skin microbiome, the situation appears to be a little more nuanced and requires a familiarity with what has become known as the biogeography of the skin.
If the skin is viewed as an ecological landscape, it can be divided into roughly three different regions with unique environmental characteristics: dry, moist and sebaceous regions (see Table 1). Each of these habitats attracts particular types of microbes to take up residence – what is often referred to as the skin’s biogeography.
 Table 1. Microbial Distribution Across Skin Microenvironments; adapted from works of Byrd, et al., and Carvalho, et al.7, 8
Table 1. Microbial Distribution Across Skin Microenvironments; adapted from works of Byrd, et al., and Carvalho, et al.7, 8
For example, oil-rich sebaceous sites are prime real estate for C. acnes. Moist sites see flourishing populations of Staphylococcus and Corynebacterium species. Dry regions tend to be considerably more diverse as to the scope of microbes that take up residence.7, 8 Of note, many viruses that have been detected on the skin to date do not demonstrate a preference for one microenvironment over another.7 Therefore, taking the example of the sebaceous microenvironments normally dominated by Cutibacteria, an increase in bacterial diversity would be outside what’s normal for that biogeographic region of the skin.
In contrast, microbial diversity is consistent with dry areas of the skin such as the feet that notably are often in direct contact with the external environment. Therefore, assumptions of increased microbial diversity translating to improved skin health must be moderated in the context of which part of the skin is under consideration. While diverse inhabitants would be considered normal in dry regions, this is certainly not the case with sebaceous sites.
The real root cause of microbiota-associated skin conditions is the incidence of a dysbiosis, which refers to a disruption in the population levels of the microbes found on normal, healthy skin. Increases and decreases of specific microorganisms have been associated with the development of various skin conditions; for example, several biological models of atopic dermatitis have highlighted an increased growth of Staphylococcus aureus coupled with diminished levels of S. epidermidis.
In the case of acne vulgaris, some models suggest the pathogenesis of this condition is spurred by either overall increased C. acnes growth or selective increases in the levels of particularly acneic strains of C. acnes. Given that C. acnes and S. epidermidis usually occupy similar niches of the skin biogeography, a disproportionate growth of one is likely to have consequent impacts on the other.
As such, countermeasures targeting C. acnes populations will sometimes inadvertently produce a limited surge in S. epidermidis levels. Any dysbiosis will have ripple effects through several microbial populations, therefore their interconnectedness must be considered when developing solutions to restore original homeostatic levels.
Good and Bad Actors
C. acnes and S. epidermidis are two of the most ubiquitous bacterial species detected on the skin across multiple regions (see Table 1). They are constituents of the normal, healthy skin microbiota.9 Indeed, these two bacteria have demonstrated some beneficial impacts on skin health. The lipolytic enzymatic activity associated with C. acnes produces short chain fatty acids that contribute to the acid mantle of the skin that is known to impede the growth of problematic, opportunistic bacteria such as S. aureus. Since S. aureus has multiple skin disease associations, it can be inferred that this aspect of the C. acnes lifecycle promotes health by keeping this microbial pathogen in check.
S. epidermidis produces an enzyme known as a sphingomyelinase that facilitates the formation of ceramides – molecules that reinforce the skin barrier. Logically, the strengthening of the skin barrier protects against penetration by opportunistic microbes, increases skin resiliency and prevents trans-epidermal water loss (TEWL). Yet, both C. acnes and S. epidermidis have also been implicated as microbial culprits involved in the development of two different skin diseases: acne vulgaris and atopic dermatitis, respectively.10 Therefore, curtailing the populations of either of these resident microbes to counter associated skin conditions could have unintended consequences.
The microbe most easily classified as a “bad actor” is the aforementioned S. aureus. It has been frequently isolated at elevated levels from the skin lesions of individuals afflicted by atopic dermatitis and atopic eczema.8 S. aureus is detectable on the skin of about one-third of all humanity, usually in the region of the nares (the nostrils). As such, roughly one-third of the population is at risk for potentially worse infections by this opportunistic pathogen.
Interestingly, for some individuals, S. aureus dominates the skin below one of the nostrils while on the opposite side, a non-S. aureus species will be found (see Figure 1). Such odd patterns are detectable by standard culture-dependent techniques using mannitol-salt agar medium. Staphylococci species are particularly tolerant of high salt levels such as those on the skin, so they are one of the few genera of bacteria that can grow on mannitol-salt medium. S. aureus is the only Staphylococcus species that can ferment mannitol, which increases the acidity, making the phenol red pH indicator in the medium change color from red to yellow.
Figure 1. Mannitol salt agar plate incubated with swabs from the nares (nostrils) of an individual with S. aureus growth for the left side and non-S. aureus species growth on the right
Figure 1. Mannitol salt agar plate incubated with swabs from the nares (nostrils) of an individual with S. aureus growth for the left side and non-S. aureus species growth on the right
In Figure 1, S. aureus is easily distinguished by the yellow-colored growth pattern observed for the left nostril, while the right one exhibits the growth of an alternative Staphylococcus species that cannot ferment mannitol. The close proximity of the two populations highlights the necessity for delicate, precise microbiome modulatory strategies such that collateral damage is not inflicted on a beneficial group of microbes.
Intriguingly, enhanced growth of either or both C. acnes and S. epidermidis can impede the spread of S. aureus, thus providing a solution for the curtailment of one of the few “bad actors” on the skin.9 The augmented growth of either C. acnes or S. epidermidis could be affected by interventions such as prebiotics or probiotics, which are further expanded upon next.
Prebiotics
Of the three groups of microbiome-modulating materials described here, the prebiotics category is the most widely used. It is also perhaps the most nebulous of the three, in terms of distinction. In the broadest sense, a topical prebiotic is intended to influence the growth of one or more of the members of the skin microbiota. This definition becomes problematic, as skin care research has increasingly shown that ordinary topical ingredients can impact the growth of microbes on the skin regardless of whether they were intended to do so.11 For example, many of the component materials of skin moisturizers are excellent nutrients for certain microbes to flourish, particularly in the context of popular “preservative-free” materials.
As with many other microbiome terminologies, prebiotic also originated with the gut microbiome. Its official definition was established in 2017 as, “a substrate that is selectively utilized by host microorganisms conferring a health benefit.”12 Take, for example, the sugar sucrose. Sucrose promotes the growth of S. epidermidis, which has been shown to repel the growth of C. acnes cultures. As such, topically applied sucrose was confirmed to diminish lesions associated with acne vulgaris in a mouse model system, where S. epidermidis flourished at the expense of C. acnes.13
In this case, the topical application of sucrose represents a prebiotic solution to counter the incidence of acne vulgaris. While this represents an oversimplified prebiotic solution to promote the growth of one member of the skin microbiota at the expense of another, what about the complex mixture of cosmetic products that we utilize as part of our routine hygiene? Certainly, many of these materials impact the growth of members of the skin microbiota – as a benefit to some, detriment to others.
A significant scientific study was published describing the long-term effects of various commonplace skin care products on the skin microbiota. The manuscript employed two avenues of analysis – one chemical and one microbiological. Using mass spectrometry, the authors were able to show that various cosmetic care products, such as deodorants and antiperspirants, persisted on the skin of participants for weeks following a single application of the materials.11
This investigation confirmed that alterations in personal hygiene practices can modulate the chemistry of the skin and thereby alter the resident microbes. For example, the authors determined that the armpits of the average individual exhibit high levels of both Corynebacterium and Staphylococcus species, comprising approximately 80% of the armpit microbiota. Following the cessation of deodorant or antiperspirant use, the relative levels of Corynebacteria and Staphylococci increased significantly.11
In contrast, re-commencing the use of deodorants and antiperspirants resulted in diminished populations of the aforementioned bacterial groups, with proliferation in a variety of other bacterial species and an overall increase in bacterial diversity. Many spikes in growth were of bacteria that are normally low in abundance. When the normal hygiene routine was restored, however, the bacterial community returned similarly to what it was before the study was initiated.11 Findings such as these provoke questions about what the normal state of microbial diversity is in healthy skin.
Probiotics
Advances in early gut microbiome research prompted the World Health Organization (WHO) in 2001 to define probiotics as, “live microorganisms which when administered in adequate amounts, confer a health benefit on the host.”14, 15 Put simply, topical probiotics are living microorganisms applied to the skin that confer some benefit by their presence and expanded growth.
Much of our knowledge of the skin microbiome is skewed within the context of bacterial members due to the biased influence of 16S rRNA sequencing of the microbiota. Therefore, many efforts have been based on bacteria and, to a much lesser extent, archaea. So, while probiotic interventions may claim to “improve biodiversity” on the skin and in some way bolster overall skin health, there are issues in substantiating such claims, particularly given that many of them fail to consider all members of the skin microbiota.
Perhaps the most popular live microorganism to be topically applied is the Lactobacillus genus of bacteria. There has already been considerable use of this group of Gram-positive bacteria in the foods industry as an oral probiotic supporting improved metabolism. The dairy section of a local supermarket will reveal many bacterial species – some Bifidobacterium, but mostly Lactobacilli: L. acidophilus, L. bulgaricus, L. rhamnosus and L. paracasei, to name a few.
It has almost become a competition to infuse the most species of bacteria into products. Indeed, there is ample laboratory and clinical evidence to support the gut health benefits from the addition of these microbes. One could also argue that skin will see positive outcomes from the so-called gut-skin axis, which is another area continuing to be explored.16
But how do Lactobacillus species perform in the context of skin? These bacteria are not normally detected in high levels on human skin but are certainly a significant component of the microbiota of other sites on and in the human body. In fact, the presence of high levels of Lactobacillus species is one of the microbiome signatures of a natural birth, compared with a Caesarian section, where more common skin bacteria are acquired, such as S. epidermidis.17
Yet, there is clinical evidence that live Lactobacillus bacteria as well as lysates (dead, ruptured bacteria) can provide a variety of benefits when employed as a topical probiotic. This includes skin hydration, reduced inflammation, increased antimicrobial peptide production and countering skin conditions associated with S. aureus, C. acnes and Candida albicans, among other effects.18-21
One probiotic for improved skin health employs a rather ubiquitous member of the normal skin microbiota: Micrococcus luteus. This species can be found in numerous locations on the skin and is known to produce rather large, shiny, bright yellow colonies when cultivated from a skin sample. Clinical testing has confirmed the topical application of this bacteria to be both safe and well-tolerated by skin tissue. In addition, benefits demonstrated include improved skin radiance, water retention, skin softness, reduced sebum levels and impaired growth of S. aureus.22
A probiotic approach to the microbiome cannot evade the fundamental safety concern for a large number of individuals in the global population considered to be immunocompromised. Many commensal microbes that inhabit the skin can shift from being partners to pathogens if our immune system becomes incapable of countering their potentially aggressive growth. And if it can happen with a microbial species already present on the skin, imagine the consequences of introducing a new live microbe(s) to a person in an already precarious state of health.
Postbiotics
Finally, postbiotics became a category of microbiome/skin health modulators in 2021 with the following description: “preparations of inanimate microorganisms and/or their component(s) that confer a health benefit on their host.”23 The genesis of this category was predicated on an acknowledgment that microbial lysates were being marketed as probiotics despite the fact that they did not constitute living organisms – and there was no alternative banner under which they could be listed. This was most evident with lysates of Lactobacillus species being advertised as probiotics for healthier skin.20
The postbiotic approach bypasses microorganisms almost entirely by isolating and purifying the biological molecules certain microbes produce that benefit skin health. The advantages of this include not having to consider the viability of living microbes in downstream formulations, which can also result in longer product shelf-lives. Furthermore, there are fewer safety issues than with topically applying living microorganisms.24
As noted, postbiotic materials include the lysates of killed microbes, and lysates of certain species of Lactobacillus have been reported to exert health benefits when topically applied.20, 21 Postbiotic materials can be intracellular compounds, secreted metabolites and even portions of bacterial cell walls. The ascribed benefits of these various substances include antimicrobial, anti-inflammatory, anti-proliferative and antioxidant.
Perhaps the best-described postbiotic approach is the rapidly expanding use of fermentation technology. At its core, the process of fermentation liberates beneficial molecules from complex biological material. Indeed, most postbiotic products currently being marketed are ferments. The vast majority are derived from Lactobacillus species, with Saccharomyces cerevisiae ferments being a close second.
Collectively, fermentation processes involve four generalized steps: growth of the microbe of interest, centrifugation and washing of the cells, disruption of the harvested cells and the separation/purification of the desired bioactive molecules from the cellular debris.24
Some might argue that the research and market for postbiotic bioactive ingredients is still in its infancy. However, it is difficult to deny the advantages of this approach.
Conclusions
With the unprecedented interest in the skin microbiome and desire for microbiome modulatory skin care products, it is critical that scientists leading the development of these innovative new bioactive materials properly communicate how these efforts are being leveraged. Miscommunications and contradictions will make it difficult for the industry to gain the trust of consumers and their confidence in the power of microbiome-based products.
As stated at the beginning of this article, there is some conflation between the terms microbiome and microbiota that some might consider trivial but can have a significant impact on how the ratio of microbial to human cells and their genetic contributions are estimated. Beyond issues of semantics, the cosmetic care industry should discuss these topics with careful deliberation given that the scope of our knowledge in this area is still incomplete.
The collective and individual impacts of the lesser-discussed skin inhabitants such as the archaea and resident viruses are still being deciphered. And we have yet to elucidate the origins of the so-called dark matter of the human microbiome – DNA sequences that do not have any resemblance to known genetic sequences. For some individuals, the skin microbiome can be comprised of as much as 25% of these sequences.25
Many products have been launched that purport to have microbiome modulatory effects. As described herein, these materials are often categorized as either prebiotics, probiotics or postbiotics. There is also the more recently coined term synbiotic, which represents a combination of prebiotics and probiotics, using the former to support the growth of the latter. Unfortunately, there has been conflation and misuse of these descriptors that will ultimately confuse the consumer who is trying to make informed choices regarding their skin care regimen. This should be particularly concerning for individuals with compromised immune systems who must carefully consider whether a certain probiotic solution is permissible given their health status.
Cumulatively, with the increasing importance levied upon the skin microbiome and its role in skin health, it is critical that the industry properly communicate how the research is being conducted; how the associated cosmetic care products are being developed; and the precise clinical benefit of their applications. With the magnitude of the role played by the microbiome in the pathogenesis of various skin conditions, the industry cannot afford to lose the confidence of the consumer due to accidental and unfortunate misrepresentation.
This remains an exciting time, with new discoveries in microbiome research and innovations in microbiome modulatory cosmetic care products reported regularly. These will feed into the overall microbiome market growth, projected to reach a net worth of ~$2 billion near the end of the decade.
Acknowledgments: The author wishes to thank Brianna Scacchi for fruitful discussions and her in-depth review of this manuscript.
References
1. Luckey, T.D. (1972). Introduction to intestinal microecology. Am J Clin Nutr. 25 1292-4.
2. Anonymous. (2019). After the integrative human microbiome project, what's next for the microbiome community? Nature. 569 599.
3. Gilbert, J.A., Jansson, J.K. and Knight, R. (2014). The Earth Microbiome project: Successes and aspirations. BMC Biol. 12 69.
4. Integrative HMPRNC. (2019). The integrative human microbiome project. Nature 569 641-648.
5. Sender, R., Fuchs, S. and Milo, R. (2016). Revised estimates for the number of human and bacteria cells in the body. PLoS Biol. 14:e1002533.
6. Sender, R., Fuchs, S. and Milo, R. (2016). Are we really vastly outnumbered? Revisiting the ratio of bacterial to host cells in humans. Cell. 164 337-40.
7. Byrd, A.L., Belkaid, Y. and Segre, J.A. (2018). The human skin microbiome. Nat Rev Microbiol. 16 143-155.
8. Carvalho, M.J., So, A.L., Santos Pedrosa, S., Pintado, M., Pinto-Ribeiro, I. and Madureira, A.R. (2023). Skin microbiota and the cosmetic industry. Microb Ecol. 86 86-96.
9. Fourniere, M., Latire, T., Souak, D., Feuilloley, M.G.J. and Bedoux, G. (2020). Staphylococcus epidermidis and Cutibacterium acnes: Two major sentinels of skin microbiota and the influence of cosmetics. Microorganisms. 8.
10. Bruggemann, H., Salar-Vidal, L., Gollnick, H.P.M. and Lood, R. (2021). A Janus-faced bacterium: Host-beneficial and -detrimental roles of Cutibacterium acnes. Front Microbiol. 12 673845.
11. Bouslimani, A., da Silva, R. … Dorrestein, P.C., et al. (2019). The impact of skin care products on skin chemistry and microbiome dynamics. BMC Biol. 17 47.
12. Gibson, G.R., Hutkins, R., … Reid, G., et al. (2017). Expert consensus document: The International Scientific Association for Probiotics and Prebiotics (ISAPP) consensus statement on the definition and scope of prebiotics. Nat Rev Gastroenterol Hepatol. 14 491-502.
13. Maguire, M. and Maguire, G. (2017). The role of microbiota, and probiotics and prebiotics in skin health. Arch Dermatol Res. 309 411-421.
14. McLoughlin, I.J., Wright, E.M., Tagg, J.R., Jain, R. and Hale, J.D.F. (2022). Skin microbiome-The next frontier for probiotic intervention. Probiotics Antimicrob Proteins. 14 630-647.
15. Mack, D.R. (2005). Probiotics-mixed messages. Can Fam Physician 51 1455-7, 1462-4.
16. Sinha, S., Lin, G. and Ferenczi, K. (2021). The skin microbiome and the gut-skin axis. Clin Dermatol. 39 829-839.
17. Neu, J. and Rushing, J. (2011). Cesarean versus vaginal delivery: Long-term infant outcomes and the hygiene hypothesis. Clin Perinatol. 38 321-31.
18. Delanghe, L., Spacova, I., Van Malderen, J., Oerlemans, E., Claes, I. and Lebeer, S. (2021). The role of lactobacilli in inhibiting skin pathogens. Biochem Soc Trans. 49 617-627.
19. Muizzuddin, N., Maher, W., Sullivan, M., Schnittger, S. and Mammone, T. (2012). Physiological effect of a probiotic on skin. J Cosmet Sci. 63 385-95.
20. Jung, Y.O., Jeong, H., … Lim, K.M., et al. (2019). Lysates of a probiotic, Lactobacillus rhamnosus, can improve skin barrier function in a reconstructed human epidermis model. Int J Mol Sci. 20.
21. Khmaladze, I., Butler, E., Fabre, S. and Gillbro, J.M. (2019). Lactobacillus reuteri DSM 17938-A comparative study on the effect of probiotics and lysates on human skin. Exp Dermatol. 28 822-828.
22. Jain, R., Voss, A.L., Tagg, J.R. and Hale, J.D.F. (2022). Evaluation of the preliminary safety, tolerability and colonization efficacy of topical probiotic formulations containing Micrococcus luteus Q24 in healthy human adults. Cosmetics 9 1-15.
23. Salminen, S., Collado, M.C., Endo, …Vinderola, G., et al. (2021). The International Scientific Association of Probiotics and Prebiotics (ISAPP) consensus statement on the definition and scope of postbiotics. Nat Rev Gastroenterol Hepatol. 18 649-667.
24. Duarte, M., Oliveira, A.L., Oliveira, C., Pintado, M., Amaro, A. and Madureira, A.R. (2022). Current postbiotics in the cosmetic market-an update and development opportunities. Appl Microbiol Biotechnol. 106 5879-5891.
25. Modha, S., Robertson, D.L., Hughes, J. and Orton, R.J. (2022). Quantifying and cataloguing unknown sequences within human microbiomes. mSystems 7:e0146821.












